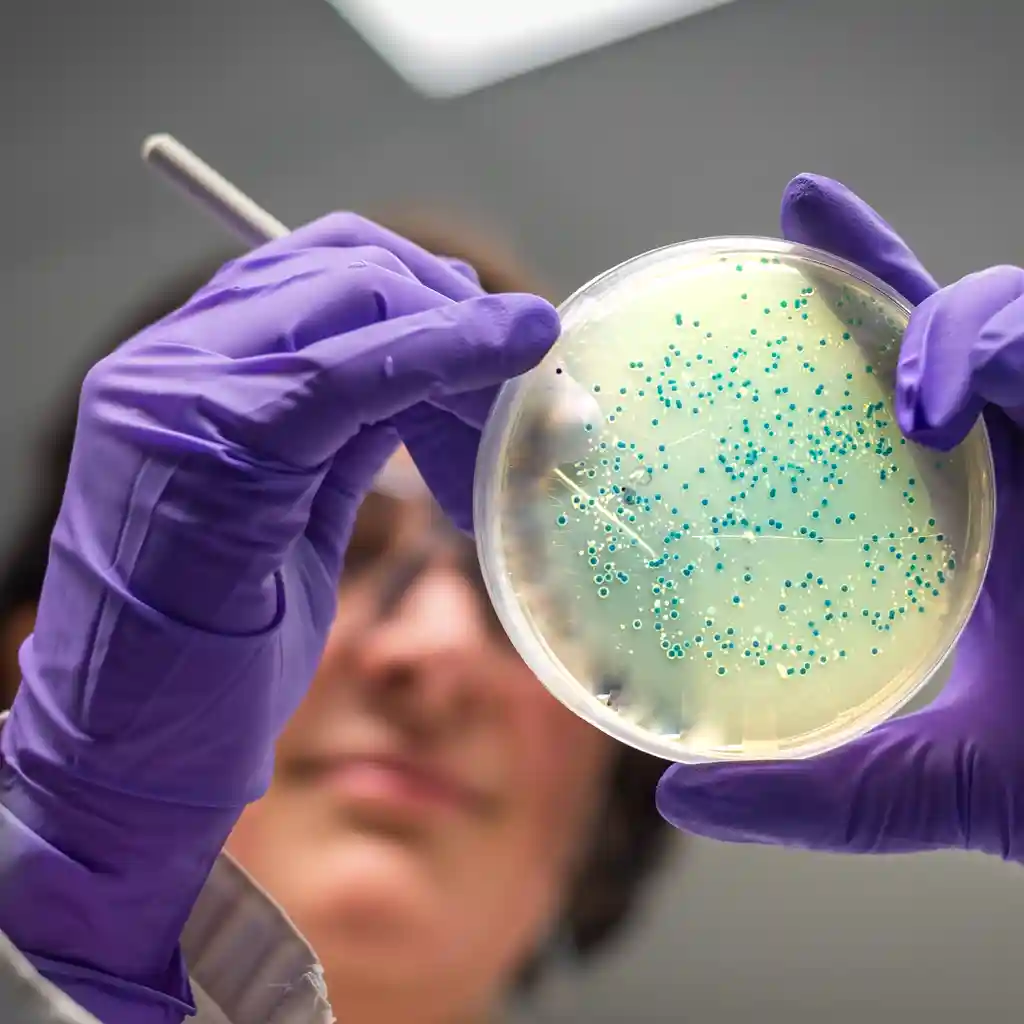

00984-7288-822
علاجات جراحة العظام والروماتيزم
طب العظام وأمراض الروماتيزم في ميدي سفر
تقدم خدمات ميدي سفر الطبية المتطورة مساعدة للمرضى الذين يعانون من اضطرابات العظام والروماتيزم، وتعالج مشكلات العظام العضلية وأمراض الجهاز المناعي الذاتية. يتميز أخصائيو العظام في المستشفى بعلاج مجموعة واسعة من المشكلات، والتي تشمل الكسور إلى جانب استبدال المفاصل والإصابات الرياضية، بالإضافة إلى اضطرابات العمود الفقري وتشوهات الجسم.
يوفر قسم الروماتيزم في ميدي سفر حلول رعاية مبتكرة لعلاج التهاب المفاصل إلى جانب الذئبة والنقرس. يحافظ أطباء الروماتيزم في المستشفى على التعاون المستمر مع مرضاهم للتحكم في الألم وتقليل الالتهابات وحماية المفاصل التالفة. تُظهر منشأة ميدي سفر الصحية نتائج ممتازة من خلال الجمع بين الخبرة الطبية المهنية والمعدات التشخيصية المتطورة وشبكة دعم تتمحور حول المريض.
ينبغي للمرضى اختيار مستشفى ميدي سفر كخيارهم الأساسي للدعم الطبي الشامل في طب العظام وأمراض الروماتيزم

كيف تعمل الخدمة؟
Treatments in Orthopaedics & Rheumatology
تشمل العلاجات والإجراءات في جراحة العظام والروماتيزم الحالات التالية